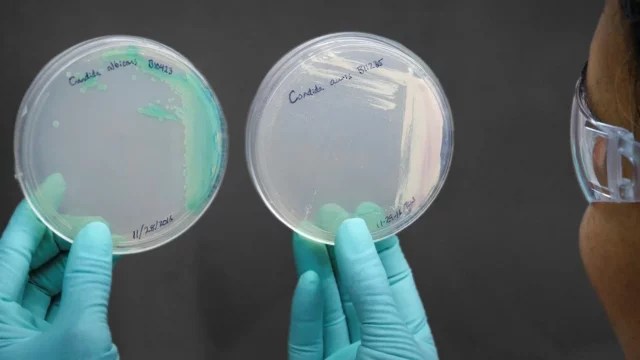

Las infecciones con el hongo Cándida auris, un microorganismo superresistente a los medicamentos y potencialmente mortal, crecieron de forma dramática en Estados Unidos entre 2019 y 2021, según un estudio publicado este lunes en la revista especializada Annals of Internal Medicine.
En concreto, los investigadores alertan del aumento de los casos que son resistentes a las equinocandinas, el principal fármaco que se utiliza para tratar las infecciones con el hongo Cándida.
Este tipo de casos fueron tres veces más frecuentes en 2021 que en los dos años anteriores, según el estudio, que analizó datos de los Centros para el Control y la Prevención de Enfermedades (CDC, en inglés), así como los recogidos por las autoridades sanitarias a nivel local y estatal.
Los datos muestran un aumento del porcentaje de crecimiento de las infecciones con Cándida auris, que pasó de ser del 44% en 2019 al 95% en 2021.
Para los investigadores que trabajan para los CDC, el aumento puede estar relacionado con las dificultades que la pandemia de Covid-19 ha producido en el sistema sanitario, como la escasez de sanitarios o el uso de más medicamentos antimicrobianos.
El informe enfatiza que el Cándida auris, que se detectó por primera vez en Estados Unidos en 2016, está catalogado como “amenaza urgente” por los CDC, debido a su resistencia a los medicamentos y su alta tasa de mortalidad.
La mayoría de casos se dan en centros sanitarios, sobre todo entre pacientes que llevan mucho tiempo ingresados o que están conectados a ventiladores mecánicos, explican los autores.
Información. Forbes.